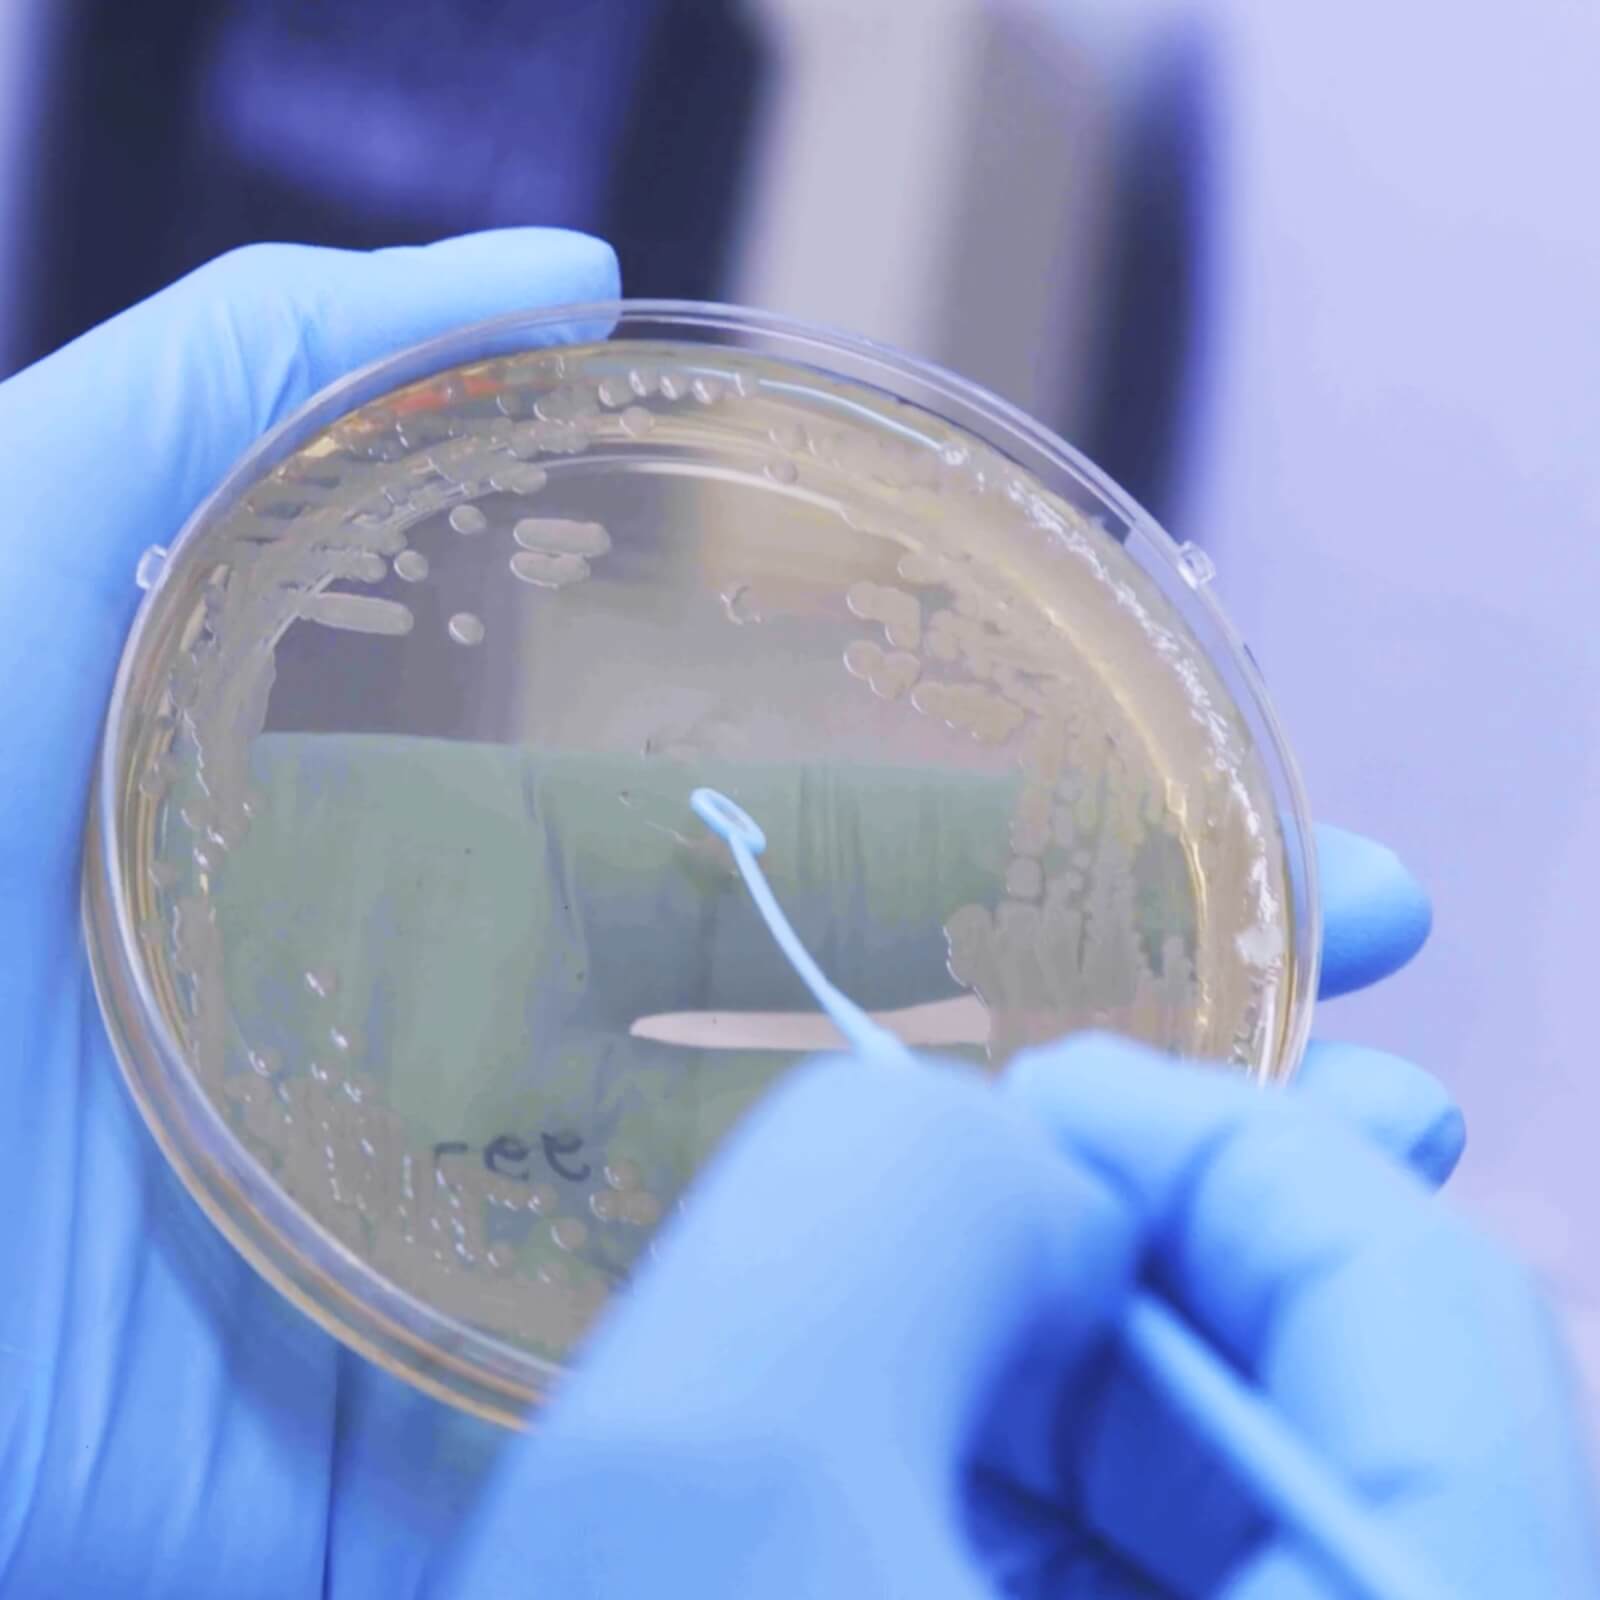
detail laboratory research biotech

BIOTECH MANUFACTURING INNOVATION
BIOTECH MANUFACTURING INNOVATION
The Infinite Alpha:
the naming of Anemocyte is the result of the combination of the words “ánemos” and “cyte”.
From this union, the Infinite Alpha is created, a symbol that incorporates the values of the company, its DNA.
Soul & Science.
Meet the Anemocyte’s genesis

More than 20 years of experience
MORE THAN 20 YEARSOF EXPERIENCE
ANEMOCYTE is a Biotech Manufacturing Organization (BMO) with a strong and dedicated focus on the contract development and manufacturing of Plasmids (for Viral Vector and mRNA manufacturing – High Quality and GMP) and mRNA.
More than 20 years of development and manufacturing experience (from R&D to GMP) in the field of Cell and Gene Therapies and Nucleic Acids. At Anemocyte we foster a culture of Teamwork, Safety, and Strategic Growth. Learn more about our values.
PLASMID DNA & MRNAMANUFACTURING
We provide custom manufacturing solutions, combining advanced technology and expertise to meet each client’s specific needs.
PLASMID DNA & MRNAMANUFACTURING
We provide custom manufacturing solutions, combining advanced technology and expertise to meet each client’s specific needs.
Anemocyte headquarters
ANEMOCYTE HEADQUARTERS
- Strategic Position – Greater Milan Area, three international airports within 50 Km.
- Plasmid Manufacturing Unit – 500 sq. m. of cleanrooms addressing the manufacturing needs of Plasmids from R&D to GMP.